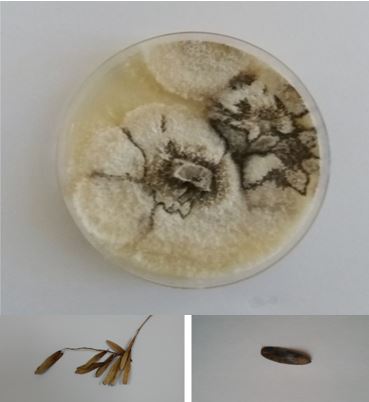

The Ecological and histological investigation of species complex Diaporthe eres on Fraxinus excelsior seed from Montenegro
DOI:
https://doi.org/10.21750/REFOR.11.02.90Keywords:
Diaporthe eres, Fraxinus excelsior, Seed, Bio ecologyAbstract
Investigation of different seed diseases of common ash has great significance due to occurrence of ash dieback across Europe caused by Hymenoscyphus fraxineus Baral, Queloz and Hosoya (T.Kowalski) and still not completely defined strategies about regeneration of this species. Species complex Diaporthe eres are familiar pathogens of common ash. During the monitoring of health condition of common ash in Montenegro Diaporthe eres was frequently isolated from common ash seeds. The aim of this research was to investigate temperature conditions that contribute to the growth of Diaporthe eres strains from Montenegro in infected seeds and histological characteristics of Diaporthe eres spread in seeds. Growth of Diaporthe eres pure cultures on tested temperatures showed the fastest growth on 25°C and the absence of growth on 35°C. Mechanical damage did not significantly contribute to occurrence of infection. Microscopic examination of heavy infected seeds showed that hyphae of D.eres were visible on outer parts of seed spreading inside the core. In this research we investigated some basic bio ecological characteristics of D. eres associated with decline of F. excelsior seed in Montenegro.
Downloads
References
Abramczyk BA, Król ED, Zalewska ED, Zimowska B (2018) Morphological characteristics and pathogenicity of Diaporthe eres isolates to the fruit tree shoots. Acta Scientiarum Pololonicum Hortorum Cultus 17(6):125-133. https://doi.org/10.24326/asphc.2018.6.13 DOI: https://doi.org/10.24326/asphc.2018.6.13
Agarwal VK, Sinclair JB (1996) Principles of Seed Pathology CRC Press, Lewis Publishers, Boca Raton, New York, London, Tokyo.
Arciuolo R, Camardo Leggieri M, Chiusa G, Castello G, Genova G, Spigolon N, BattilaniI P (2021) Ecology of Diaporthe eres, the causal agent of hazelnut defects. PLoS ONE 16(3): e0247563. https://doi.org/10.1371/journal.pone.0247563 DOI: https://doi.org/10.1371/journal.pone.0247563
Bakys R, Vasaitis R, Barklund P, Thomsen IM, Stenlid J (2009) Occurrence and pathogenicity of fungi in necrotic and non-symptomatic shoots of declining common ash (Fraxinus excelsior) in Sweden. Eur J Forest Res 128(1): 51-60. https://doi.org/10.1007/s10342-008-0238-2 DOI: https://doi.org/10.1007/s10342-008-0238-2
Castlebury LA, Rossman AY, Jaklitsch WJ, Vasilyeva LN (2002) A preliminary overview of the Diaporthales based on large subunit nuclear ribosomal DNA sequences. Mycologia 94: 1017-1031. https://doi.org/10.1080/15572536.2003.11833157 DOI: https://doi.org/10.1080/15572536.2003.11833157
Cleary MR, Arhipova N, Gaitnieks T, Stenlid J, Vasaitis R (2013) Natural infection of Fraxinus excelsior seeds by Chalara fraxinea. Forest Pathology 43(1):83-85. https://doi.org/10.1111/efp.12012 DOI: https://doi.org/10.1111/efp.12012
Ellis MB, Ellis JP (1985) Microfungi on land plants. Croom Helm, London and Sidney.
Farr DF, Castlebury LA, Rossman AY (2002) Morphological and molecular characterization of Phomopsis vaccinii and additional isolates of Phomopsis from blueberry and cranberry in the eastern United States. Mycologia 94: 494-504. https://doi.org/10.1080/15572536.2003.11833214 DOI: https://doi.org/10.1080/15572536.2003.11833214
FRAXIGEN (2005) Ash species in Europe: biological characteristics and practical guidelines for sustainable use. Oxford Forestry Institute, University of Oxford, UK.
Gomes RR, Glienke C, Videira SIR, Lombard L, Groenewald JZ, Crous PW (2013) Diaporthe, a genus of endophytic, saprobic and plant pathogenic fungi. Persoonia 31: 1-41. http://dx.doi.org/10.3767/003158513X666844 DOI: https://doi.org/10.3767/003158513X666844
Hayatgheibe H (2013) Studies on the microflora associated with the seeds of European ash (Fraxinus excelsior) and the infection biology of the pathogen Hymenoscyphus pseudoalbidus causing ash dieback. MSc thesis, Swedish University of Agriculture Sciences-Faculty of Natural Resources and Agricultural Science, Uppsala, Sweden.
Kowalski T, Bilański P, Kraj W, (2017) Pathogenicity of fungi associated with ash dieback towards Fraxinus excelsior. Plant Pathol 66(8): 1228-1238. https://doi.org/10.1111/ppa.12667 DOI: https://doi.org/10.1111/ppa.12667
Kowalski T, Kraj W, Bednarz B (2016) Fungi on stems and twigs in initial and advanced stages of dieback of European ash (Fraxinus excelsior) in Poland. Eur J Forest Res 135: 565-579. https://doi.org/10.1111/ppa.12667 DOI: https://doi.org/10.1007/s10342-016-0955-x
Linaldeddu BT, Bottecchia F, Bregant C, Maddau L, Montecchio L (2020) Diplodia fraxini and Diplodia subglobosa: The Main Species Associated with Cankers and Dieback of Fraxinus excelsior in North-Eastern Italy. Forests 11(8): 883. https://doi.org/10.3390/f11080883 DOI: https://doi.org/10.3390/f11080883
Mitchell RJ, Hewison RL, Hester AJ, Broome A, Kirby KJ (2016) Potential impacts of the loss of Fraxinus excelsior (Oleaceae) due to ash dieback on woodland vegetation in Great Britain. New Journal of Botany 6(1): 2-15. https://doi.org/10.1080/20423489.2016.1171454 DOI: https://doi.org/10.1080/20423489.2016.1171454
Mostert L, Kang JC, Crous PW, Denman S (2001) Phomopsis saccharata sp. nov., causing a canker and dieback disease of Protea repens in South Africa. Sydowia 53: 227-235.
Muntanola Cvetković M (1990) Opšta mikologija. Naučna knjiga, Beograd. [in Serbian]
Pautasso M, Aas G, Queloz V, Holdenrieder O (2013) European ash (Fraxinus excelsior) dieback – A conservation biology challenge. Biol Conserv 158: 37-49. https://doi.org/10.1016/j.biocon.2012.08.026 DOI: https://doi.org/10.1016/j.biocon.2012.08.026
Petrović K, Vidić M, Riccioni L, Đorđević V, Rajković D (2015) First report of Diaporthe eres species complex causing seed decay of soybean in Serbia. Plant Disease 99: 1186-1186. https://doi.org/10.1094/PDIS-01-15-0056-PDN DOI: https://doi.org/10.1094/PDIS-01-15-0056-PDN
Rehner, SA, Uecker, FA (1994) Nuclear ribosomal internal transcribed spacer phylogeny and host diver-sity in the coelomycete Phomopsis. Can J Bot 72(11): 1666-1674. https://doi.org/10.1139/b94-204 DOI: https://doi.org/10.1139/b94-204
Skovsgaard JP, Wilhelm GJ, Thomsen IM, Metzler B, Kirisits T., Havrdová L, Enderle R, Dobrowolska D, Cleary M, Clark J (2017) Silvicultural strategies for Fraxinus excelsior in response to dieback caused by Hymenoscyphus fraxineus. Forestry 90(4): 455-472. https://doi.org/10.1093/forestry/cpx012 DOI: https://doi.org/10.1093/forestry/cpx012
Udayanga D, Castlebury LA, Rossman AY, Chukeatirote E, Hyde KD (2014) Insights into the genus Diaporthe, phylogenetic species delimitation in the D. eres species complex. Fungal Divers 67: 203-229. DOI 10.1007/s13225-014-0297-2 DOI: https://doi.org/10.1007/s13225-014-0297-2
Wehmeyer LE (1933) The genus Diaporthe Nitschke and its segregates. University of Michigan, Studies Scientific Series. DOI: https://doi.org/10.1016/S0007-1536(33)80010-6
Vemić A (2020) Influence of mycoses on health condition of main broadleaf species in the area of ˊBiogradska goraˊ National park. Dissertation, University of Belgrade - Faculty of Forestry, Belgrade, Serbia. 137 pp. [in Serbian].
Vemić A, Tomšovský M, Jung T, Milenković I (2019) Pathogenicity of fungi associated with ash dieback symptoms of one-year-old Fraxinus excelsior in Montenegro. Forest Pathol 49(5): e12539. https://doi.org/10.1111/efp.12539 DOI: https://doi.org/10.1111/efp.12539
Downloads
Published
Issue
Section
License
Copyright (c) 2021 Aleksandar Vemić

This work is licensed under a Creative Commons Attribution 4.0 International License.
Authors who publish with this journal agree to the following terms:
- Authors retain copyright and grant the journal right of first publication with the work simultaneously licensed under a Creative Commons Attribution License CCBY that allows others to share the work with an acknowledgement of the work's authorship and initial publication in this journal.
- Authors are able to enter into separate, additional contractual arrangements for the non-exclusive distribution of the journal's published version of the work (e.g., post it to an institutional repository or publish it in a book), with an acknowledgement of its initial publication in this journal.
- Authors are permitted and encouraged to post their work online (e.g., in institutional repositories or on their website) prior to and during the submission process, as it can lead to productive exchanges, as well as earlier and greater citation of published work (See The Effect of Open Access).



